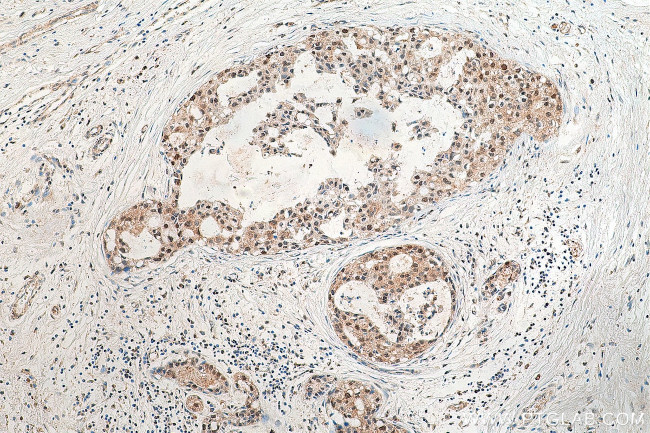
DSN1 Antibody in Immunohistochemistry (Paraffin) (IHC (P))

Search
Proteintech
DSN1 Polyclonal Antibody
{{$productOrderCtrl.translations['antibody.pdp.commerceCard.promotion.promotions']}}
{{$productOrderCtrl.translations['antibody.pdp.commerceCard.promotion.viewpromo']}}
{{$productOrderCtrl.translations['antibody.pdp.commerceCard.promotion.promocode']}}: {{promo.promoCode}} {{promo.promoTitle}} {{promo.promoDescription}}. {{$productOrderCtrl.translations['antibody.pdp.commerceCard.promotion.learnmore']}}
产品信息
17742-1-AP
种属反应
已发表种属
宿主/亚型
分类
类型
抗原
偶联物
形式
浓度
规格
纯化类型
保存液
内含物
保存条件
运输条件
产品详细信息
Immunogen sequence: MSKTHDHQL ESSLSPVEAF AKTSASLEMN QGVSEERIHL GSSPKKGGNC DLSHQERLQS KSLHLSPQEQ SASYQDRRQS WRRASMKETN RRKSLHPIHQ GITELSRSIS VDLAESKRLG CLLLSSFQFS IQKLEPFLRD TKGFSLESFR AKASSLSEEL KHFADGLETD GTLQKCFEDS NGKASDFSLE ASVAEMKEYI TKFSLERQTW DQLLLHYQQE AKEILSRGST EAKITEVKVE PMTYLGSSQN EVLNTKPDYQ KILQNQSKVF DCMELVMDEL QGSVKQLQAF MDESTQCFQK VSVQLGKRSM QQLDPSPARK LLKLQLQNPP AIHGSGSGSC Q (1-340 aa encoded by BC026011)
靶标信息
Part of the MIS12 complex which is required for normal chromosome alignment and segregation and kinetochore formation during mitosis.
仅用于科研。不用于诊断过程。未经明确授权不得转售。
生物信息学
蛋白别名: DSN1 homolog, MIS12 kinetochore complex component; DSN1, MIND kinetochore complex component, homolog; DSN1, MIS12 kinetochore complex component; kinetochore null 3 homolog; Kinetochore-associated protein DSN1 homolog; RP3-469A13.1; unnamed protein product
基因别名: 1700022L09Rik; AW552447; C20orf172; dJ469A13.2; DSN1; hKNL-3; KNL3; MIS13
UniProt ID: (Human) Q9H410, (Mouse) Q9CYC5
Entrez Gene ID: (Human) 79980, (Mouse) 66934, (Rat) 499933